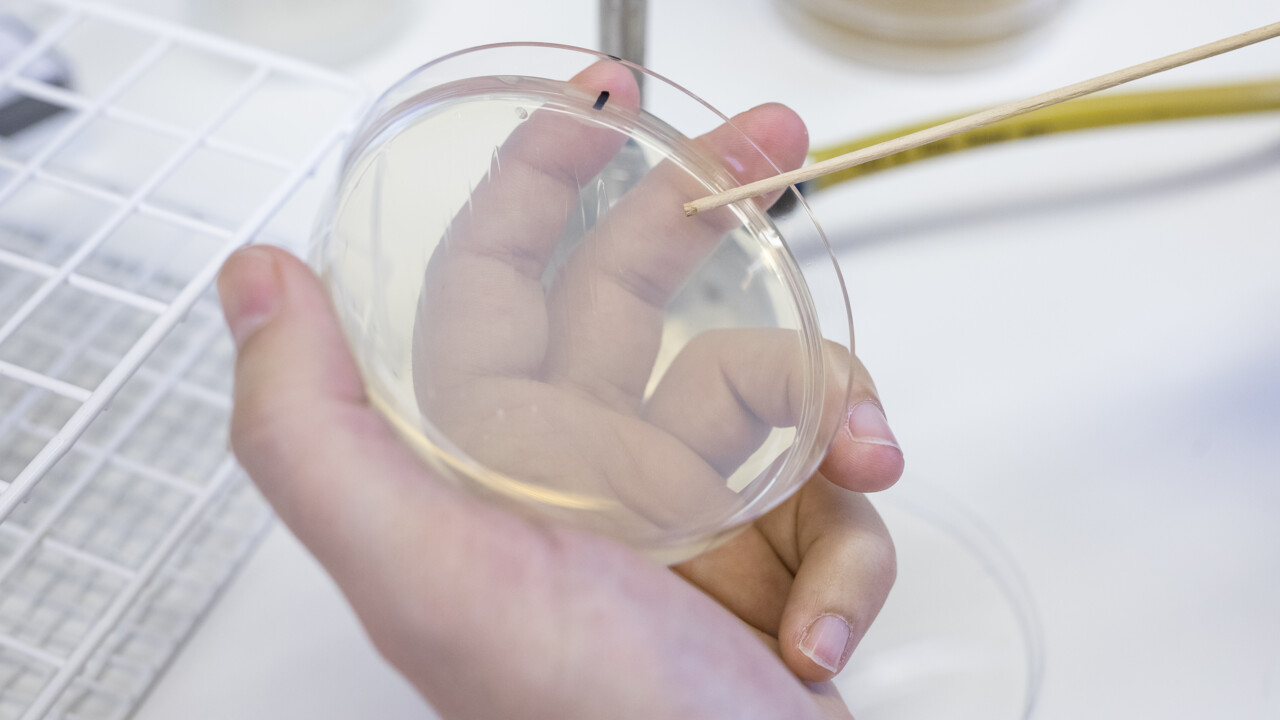
Glenn Björk
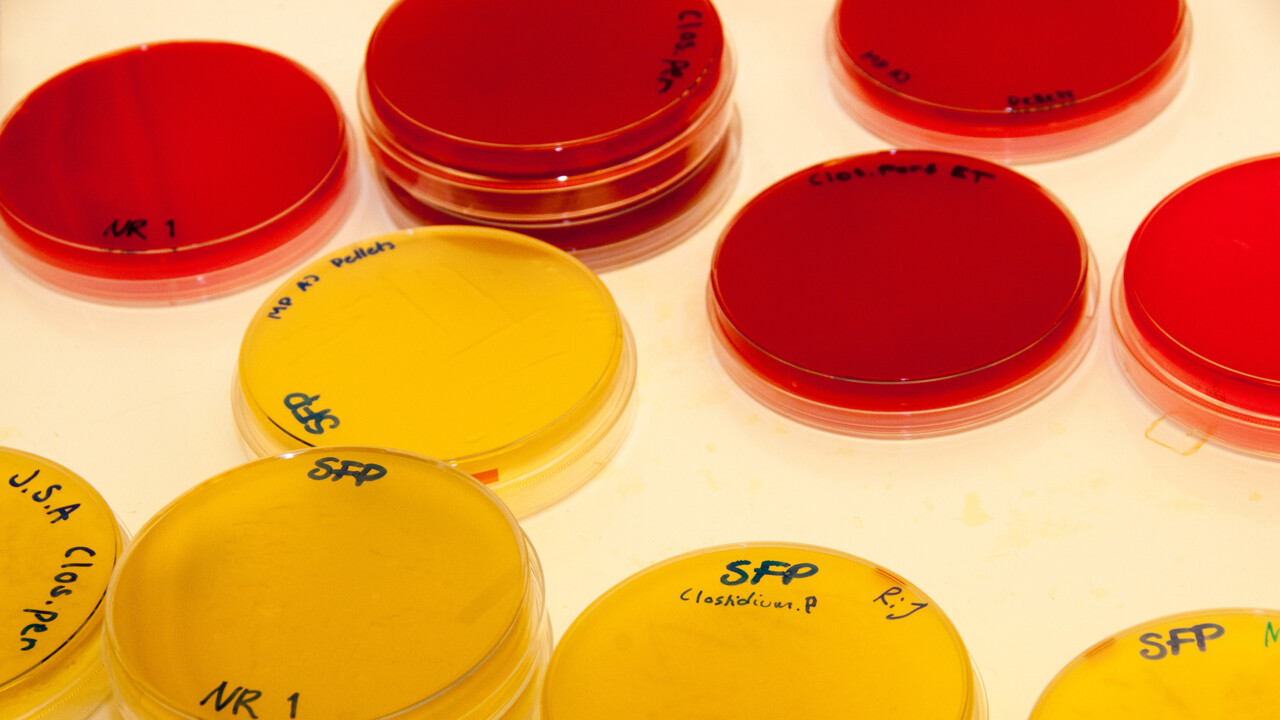

Du surfar just nu på en begränsad version av umu.se. Vad innebär det här?
UCMR omfattar 65 aktiva forskargrupper från elva institutioner vid medicinska fakulteten och teknisk-naturvetenskaplig fakultet.

Clas Ahlm studerar Covid-19 och hantavirusinfektion, vilka båda smittar via lungorna.

Design och syntes av biologiskt aktiva föreningar mot infektions- och neurodegenerativa sjukdomar.

Studerar effekterna av ökat organiskt material på marina födovävar och predationsresistenta bakterier.

Gruppen utvecklar och applicerar avancerade optiska tekniker för att studera biologiska system.

Utvecklar synkrotron-baserad tidsupplöst röntgenmetodologi och studerar proteindynamik hos membranproteiner.

Vi studerar vilken roll mikroproteiner och oordnade proteiner spelar i medfödda immunprocesser.

Vi forskar om de molekyler och mekanismer som virus använder för att ta sig in i och infektera våra celler.

Vår grupp studerar mekanismer för stokastisk och kontrollerad reglering av Helicobacter pylori-adhesiner.

Vi använder ett experimentellt systembiologiskt tillvägagångssätt för att studera mikrobiella infektioner.

Vår grupp forskar om virus-membrane-interaktioner.

Infektions- och virulensegenskaper hos Borrelia spirochetes och den intracellulära parasiten Chlamydia.

Gruppen forskar om strukturbiologi av gram-positiva typ 4 sekretionssystem.

Gruppen studerar hur malariaparasiter sprider sig mellan värd och mygga och deras reproduktion.

Gruppen forskar om molekylära mekanismer för interaktioner mellan malariaparasit och värd.

Vår grupp studerar strukturer och mekanismer för virala replikationskomplex.

Utvecklar bioinformatiska metoder för att övervaka och bekämpa spridningen av bakteriella patogener.

Bakteriell cellväggssammansättning och dess bidrag till långvariga och framväxande infektionssjukdomar.

Vi forskar om akut och kronisk syrgasdetektion i nematoden C. elegans.

Vår grupp studerar mänskliga tarmmikrober med hög upplösning för att undersöka funktionella skillnader.

Gruppen utvecklar nya typer av antivirala och antibakteriella substanser.

Vi forskar på virus som överförs från djur eller myggor. Dessutom utvecklar vi antivirala läkemedel.

Forskningen fokuserar på hjärt-kärl-komplikationer under sorkfeber och de mekanismer som ligger bakom.

Vi karakteriserar hur humana B-celler i cirkulation och vävnader påverkas av underliggande sjukdom.

Francis laboratorium har som ambition att förstå bakteriers fysiologi och patogenes.

Vi forskar om bakteriella genotoxiners roll vid modulering av homeostas i slemhinnan.

Gruppen forskar om molekylära mekanismer involverade i bakteriell uthållighet i värdvävnad.

Vi använder NMR-metoder för att förstå funktion av biologiska membran, deras proteiner samt roll i sjukdomar.

Klinisk infektionsforskning med fokus på harpest samt translationell antibiotikautveckling gentemot gonorré.

Vi forskar om nya antibakteriella strategier mot intracellulära klamydiabakterier.

Vi utvecklar kemiska verktyg för att undersöka infektionsmekanismer på molekylär nivå.

Vår grupp fokuserar på att förstå hur alla processer i T-celler hänger ihop.

Vi studerar biosyntesvägar för nukleotider i T. brucei, G. lamblia, Borrelia burgdorferi och andra patogener.

Stressreglerande mekanismer och RNA-medierad reglering i bakteriepatogenen Listeria monocytogenes .

Implikationer av åldrande och sjukdom på cellulär proteinkvalitetskontroll.

Vi studerar hur luftvägs- och enteriska virus infekterar och påverkar värden.

Samspelet mellan immunförsvar och ämnesomsättning vid svåra infektioner som sepsis och covid-19.

Skulptering av membraner är grundläggande för många cellulära processer och fel kan leda till olika sjukdomar.

Vi studerar ljus-materia-interaktioner och ultrasnabba fenomen i material och molekyler på nanoskalan

Vår grupp studerar hur proteiner fungerar och interagerar i bakteriearter i människans tarmflora.

Vår grupp studerar nya onkolytiska adenovirus 11p-vektorer vid behandling av humana solida tumörer.

Studerar processer som driver diversifieringen av antigenigenkänningsmolekyler i immunsystemet.

Effektormolekyler utsöndrade av bakterier: Roll i värdpatogenes och biotekniska tillämpningar.

Vår forskning handlar om immunologiska och metabolomiska svar på akuta infektioner och vaccination.

Vi studerar mekanismer hos bakterien A. actinomycetemcomitans i samband med parodontala sjukdomar.

Vår grupp studerar struktur och funktion av bakteriella virulensfaktorer.

Vi forskar om C. difficile-infektioner och hur tarmfloratransplantation bäst botar dem.

Molekylära och biokemiska mekanismer bakom viral replikation och hur virus bryter ner värdceller.

Studerar skelettproteiner och proteinkomplex i bakterier på nanonivå.

Strukturbiologi och bioinformatik för att förstå processer i proteiner: veckning, stabilitet, interaktioner.

Hur påverkar diet vår tarmflora? Och vilka konsekvenser har detta för slemhinnans barriärfunktion?

Vår forskning fokuserar främst på bakteriepatogenen Chlamydia trachomatis.

Forskar på folkhälsa, global hälsa och infektionsepidemiologi.

Vi forskar om francisella tularensis typ VI sekretionssystem - dess struktur och reglering.

Forskar om varför vissa drabbas av kroniska infektionssjukdomar och hur tandvård ska individualiseras.

Avancerad dataanalys för att förstå komplexa biologiska system mha datadrivna modelleringsverktyg.

I vår forskargrupp studerar vi virusförekomst och roll vid sjukdom hos människa.

Bakteriella fitnessmekanismer hos patogena varianter av E. coli och opportunistiska A. baumannii.

Vår grupp är intresserad av de grundläggande processerna vid infektioner med patogena svampar.

Klargöra mekanismer och vägar modulerade av bakterier i värdceller genom frisättning av protein.

Vi forskar om molekylära verktyg för att kartlägga bakteriers interaktioner med värdmucinen O-glykom.

Vår forskning fokuserar på interaktioner mellan virus-mygga och mygga-värd.

Forskargrupp vid institutionen för Ekologi, miljö och geovetenskap Forskningsområde: Marin ekologi

Vi forskar om de komplexa kopplingarna mellan proteindynamik och biologisk funktion.

Undersöker med kemiska och kemo-optogenetiska metoder autofagi och membrantrafik reglerad av GTPaser.

Gruppen forskar om hur det fästingburna TBE-viruset sprider sig.

Forskningsledare som tidigare varit UCMR PI.
professor emeritus på institutionen för molekylärbiologi

Gruppens forskning handlar om herpesvirus och dess roll i utvecklandet av Alzheimers sjukdom.

Vår grupp studerar infektionssjukdomar och klimatförändring i norr.

Vår grupp studerar molekylära mekanismer för typ III sekretionssystem.

Vår grupp forskar om tjock- och ändtarmscancer och biomarkörer för prognos.

Vår grupp studerar virulens och överlevnad av fiskbakterien Vibrio anguillarum.

För närvarande arbetar vi främst med plasminogenens roll i sårläkning.

Vi designar och identifierar ämnen som kan hämma bakteriell virulens samt avveckla deras verkningsmekanism.

Vi forskar om bakteriell signalavkänning och integration.

Göran Wadell, professor emeritus på Institutionen för klinisk mikrobiologi.
Forskar om typ III-utsöndringssystemet hos patogenen Yersinia.